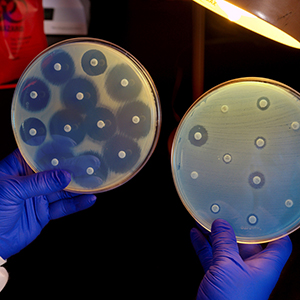

You are here
Vital Signs: Making Health Care Safer
Did you know that an increasing number of germs no longer respond to the drugs designed to kill them? According to the U.S. Centers for Disease Control and Prevention (CDC), antibiotic-resistant germs cause more than two million illnesses and at least 23,000 deaths each year in the United States. Inappropriate prescribing of antibiotics and lack of infection control actions can contribute to drug resistance and put patients at risk for deadly diarrhea (caused by C. difficile) and other infections. Even if one facility is following recommended infection controls, germs can be spread inside and between health care facilities when patients are transferred from one facility to another without appropriate actions to stop transmission.
Did you know that an increasing number of germs no longer respond to the drugs designed to kill them? According to the U.S. Centers for Disease Control and Prevention (CDC), antibiotic-resistant germs cause more than two million illnesses and at least 23,000 deaths each year in the United States. Inappropriate prescribing of antibiotics and lack of infection control actions can contribute to drug resistance and put patients at risk for deadly diarrhea (caused by C. difficile) and other infections. Even if one facility is following recommended infection controls, germs can be spread inside and between health care facilities when patients are transferred from one facility to another without appropriate actions to stop transmission.
This public health issue is the focus of the latest Vital Signs report from CDC, which includes mathematical modeling that projects increases in drug-resistant infections and C. difficile if we fail to implement immediate, nationwide improvements in infection control and antibiotic prescribing. The report emphasizes that the lack of coordination between facilities can put patients at increased risk.
There is good news from this report as well. CDC projections estimate that national infection control and antibiotic stewardship efforts led by federal agencies, health care facilities and public health departments could prevent 619,000 antibiotic-resistant and C. difficile infections and save 37,000 lives over five years.
The report recommends the following two-part approach to turn this data into action that prevents illness and saves lives:
- Public health departments track and alert health care facilities to drug-resistant germ outbreaks in their area and the threat of germs coming from other facilities, and
- Health care facilities work together and with public health authorities to implement shared infection control actions to stop the spread of antibiotic-resistant germs and C. difficile between facilities.
The CDC Foundation supports CDC’s work in this area through the Safe Healthcare Initiative, a partnership program coordinated by CDC’s Division of Healthcare Quality Promotion and the CDC Foundation to eliminate healthcare-associated infections. Other efforts falling under this initiative include the Preventing Infections in Cancer Patients program, the Safe Injection Practices Coalition and antimicrobial stewardship programs.
Let’s all work together to make health care safer.
